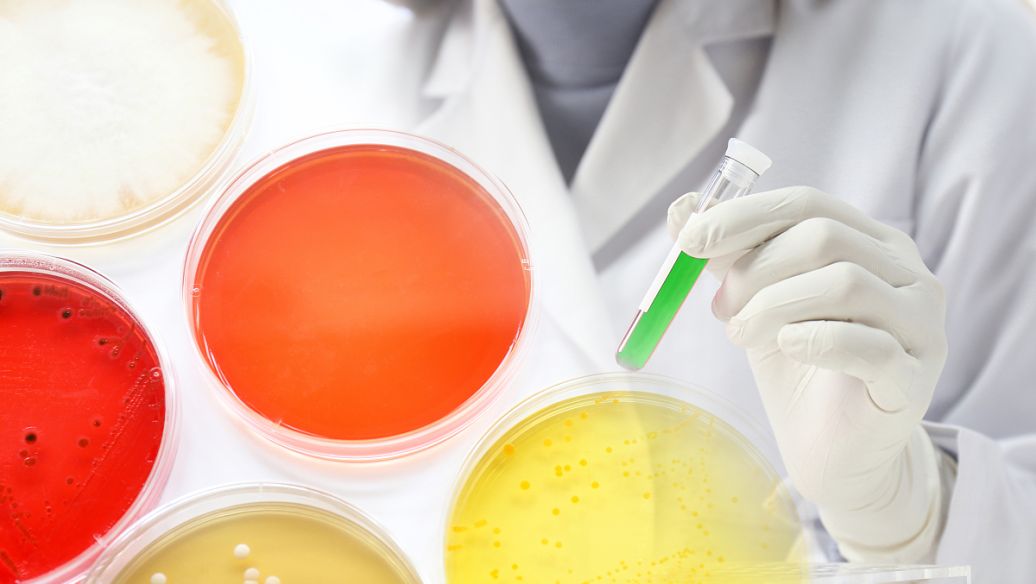
part-00538-2866.jpg

在生活中,如何才能有效地远离强直性脊柱炎,这也是很多人关心的问题。由于调查数据显示,近年来强制性脊柱炎的发病率逐步提高,因此有必要了解强直性脊柱炎的预防措施,做好预防工作。
强直性脊柱炎的预防方法是什么?这种疾病易发于男性,20至30岁的男性处于高发期。在这个人群中,如果驼背和板背有变化,我是HLA-B27阳性,我应该特别警惕强直性脊柱炎。当然,单纯的HLA-B27阳性并不一定会导致强直性脊柱炎,但在此类人群中,应积极预防肠道和泌尿道感染,并注意饮食卫生预防强直性脊柱炎。注意泌尿生殖系统的卫生。如遇上述疾病,应积极采取抗感染治疗,防止诱发性强直性脊柱炎的发生。
环境因素不容小觑,因此这类人在日常生活中一定要注意防风、防潮、防寒之害,注意每个季节的保暖,增强身体的免疫功能。古人说:善气存于记忆,恶不可干。如果邪恶聚集在一起,它的气将是空的。气是指人的体质或抗病能力。当身体充满正气时,便能抵御风寒潮湿的侵袭。如果身体虚弱不足,或者由于情绪、饮食、疲劳、内伤等原因气血虚弱,就容易生病。
强直性脊柱炎患者不宜给予过多钙。钙过多会降低血压,影响铁、锌、镁和磷的生物利用度。有些病人也可能导致肾结石。儿童补钙过多危害尤其严重,会导致过早钙化和骨闭合,限制身高,使他们将来有患心脏病的危险。补钙不是越多越好,重要的是要看吸收情况。每次服用200毫克以上的元素钙,会降低吸收率。强直性脊柱炎补钙要慎重。补钙前在正规医院检查钙含量。不要只依赖于药店内放置的单光子骨密度仪,这是不准确的。它的辐射会对病人的身体产生影响。缺钙测定后,可通过调整饮食和服用补钙产品补充钙。
南京强脊诊疗中心强直医院温馨提示:秋冬季节,易引起强直性脊柱炎的因素增多,如气温骤降,这是感冒等疾病易发的时期;季节变化,受人们情绪、心理、精神和饮食等因素的影响变化很大,强直性脊柱炎易复发或加重。因此,应提醒患者在现阶段特别注意疾病的预防和及时治疗。